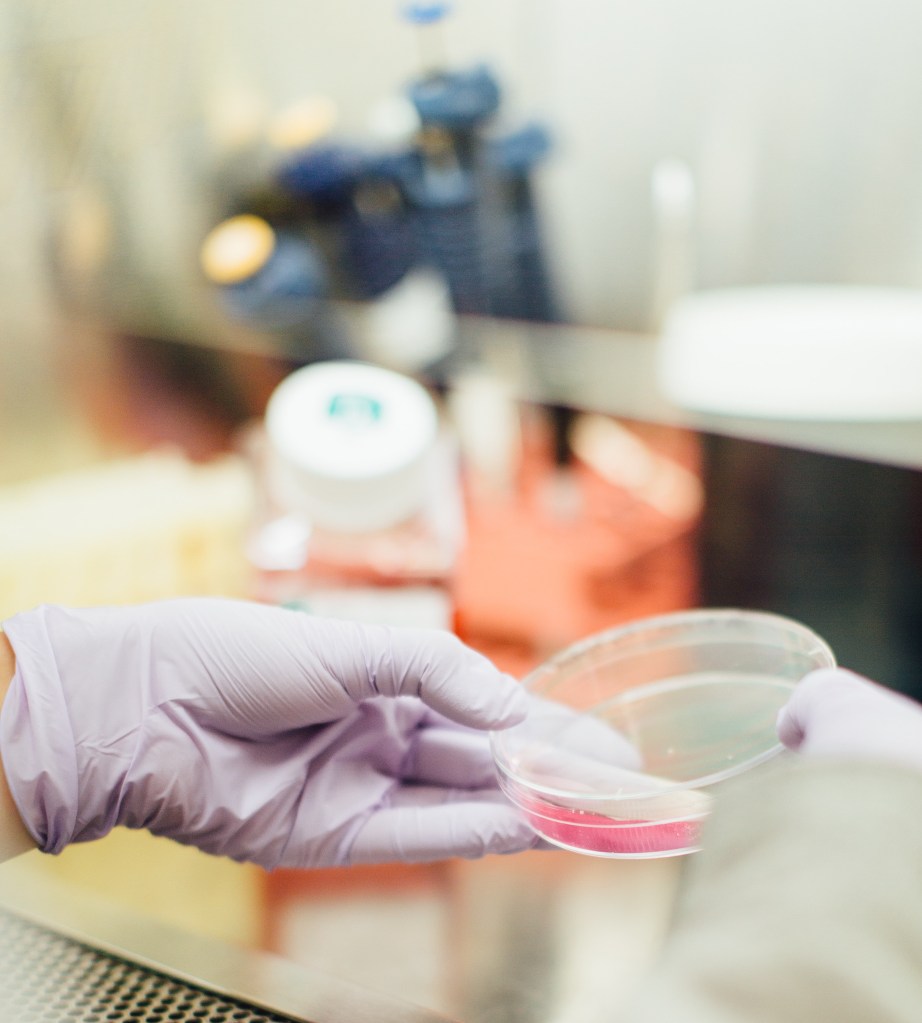
Lab research

I first crossed paths with the Athens-based dietitian Despina Marselou after attending a webinar she conducted on the effects of diet on autoimmune diseases. With a recent diagnosis of multifocal motor neuropathy, a rare degenerative condition affecting the limbs, I was desperate to discover what I could do to help myself.
I spoke to Despina initially with a view to finding out more for this article but shortly afterwards I contacted her about the role food could play in making me, as a person with an autoimmune disease, feel better. As a practitioner she is knowledgeable, open and kind.
Within a few minutes of our online consultation, Despina told me that her Greek bluntness (and here I paraphrase) might challenge my English reserve. She wasn’t wrong.
In our initial appointment, which lasted an hour, the questions I had expected – primarily about my diet – never came. Instead, we chatted about my life, back to childhood, and what circumstances surrounded the time when I felt my first symptoms. She asked questions that no other medical professional had, presumably due to time constraints, and it felt good. It felt very good. I left our chat inspired, and feeling decidedly empowered around my own health, in a way I hadn’t done before.
In terms of my diet, I was already a long-time vegan, but more the fast-food munching kind than the “clean” unprocessed food type. I wanted to understand how the change to a wholefood plant-based diet (WFPB) could work for me.
Greek-born Despina received an MSc in clinical nutrition and immunology from the University of Surrey in England, specialising in dietary support and behaviour modification in patients with disorders such as diabetes, cancer and autoimmune diseases. She believes fervently that a wholefood diet can be transformative in those with such conditions.
Here are some of the questions I put to her and her responses…
How dramatic a change can a WFPB produce? Do you often see life-changing effects in those you treat? Have you seen patients find renewed energy levels, for example?
Yes, and I am truly excited about it. Most patients who manage to adopt a plant diet can see differences in their health within four weeks. A WFPB diet is an unprocessed high-fibre diet with a variety of plants, full of the different vitamins, minerals, polyphenols and other phytochemicals. It allows balance and harmony within the diet. Everything is there: the flavours, textures and colours.
In the largest study to connect the health of the bacteria that live inside us to our diet and lifestyle – the American Gut Project – they are discovering that the most powerful predictor of a healthy gut is the diversity of plants in the diet. The American Gut Project is part of the Microsetta Initiative and operates at the Knight Lab at the UC San Diego School of Medicine. It is an active research effort in which scientists aim to work with citizen scientists, as well as academic and industry researchers.
They hope to figure out what health and lifestyle factors are associated with the composition of the microbiome, which is defined by the US National Institute of Environmental Health Sciences as “the collection of all microbes, such as bacteria, fungi, viruses, and their genes, that naturally live on our bodies and inside us”. They are in the early stages of this quest and need to collect thousands of samples to have enough data to continue looking for answers.
How did your own interest in the power of plant-based diets come about?
When I was 28 years old, I was diagnosed with Graves disease (autoimmune thyroiditis) and multiple thyroid nodules. For almost two years I experienced inexplicable daily episodes of spasm in my feet and toes, muscle weakness, brain fog and fatigue. My doctor suggested thyroidectomy to remove the suspicious thyroid nodules and put the symptoms I had at ease.
The operation was performed, but for a couple of years, despite the reassurance that all the symptoms would ease, I continued to experience most of them. As a dietitian I knew that nutrition played an important role, so I did make changes to what I was eating. I went on a gluten-free, semi-vegetarian diet, where I felt significant improvement in my physical symptoms.
However, unexpected events hit me during my second pregnancy. I was diagnosed with bilateral vestibular disease, with up to ten attacks of vertigo throughout the day and peripheral neuropathic pain. It was impossible for me to drive, work or sleep and I took at least five different expert opinions. Multiple medications and strong painkillers, including antidepressants, were the answer offered by most doctors, so it was then and there that I decided to make a big change in my life for my kids, for my family and for myself.
I decided to give some time to myself and search for alternative therapies including giving up the semi-vegetarian diet and going totally vegan. As a Mediterranean and as a dietitian, it was a huge step to take. I always thought that the key to good health was “everything in moderation” and that a whole plant-based diet was something like an elimination diet. But I must admit now that I regret not adopting a whole plant-based diet earlier.

My passion for seeking evidence-based knowledge prompted me to take the plant-based nutrition course of the biochemist T Colin Campbell, along with studying and researching food synergies. I created my own fasting nutrition protocol combined with Mediterranean herbs and teas which I followed for four months. I am thrilled to say that I have experienced robust health since then.
What was your own diet like before going plant-based?
Well, it was mostly Mediterranean, or at least I thought so. A good, healthy Mediterranean diet is mostly plant-based and mine wasn’t and there is a reason for that. In Greece, socialising with food is a big part of our culture; my husband and I used to go out a lot with friends and travel around at the weekends. So from Monday to Thursday, I was following a nice, healthy Mediterranean diet, but during weekends, I was consuming considerable amounts of fish, chicken and cheese. Oh, the cheese… I used to think there was no life without cheese.
I know you are a great believer in taking a holistic approach to disease. Is this view becoming more common among medical professionals?
Yes, and I am very happy about it.
However, we must not confuse a natural holistic approach – which means changes in your lifestyle such improvements to your sleeping pattern, socialising, adopting a whole plant-based diet, relaxing techniques such as meditation, yoga and so on – with approaches that frequently include dozens of test kits (to check your genes, microbes, nutrient absorption, etc).
There are so many online adverts for simple food allergy testing. These can lead a patient to forget all about real and natural changes, and go on a gluten-, grain-, phytate-, lectin-, oxalate-, nightshade-free food regime until the same “experts” discover another secret to human health that we’ve all been missing and end up with multiple supplements and no health change! We don’t want more restrictions or more supplements. We need real food and to feel ourselves again.
Do many of your nutritionist colleagues feel the same as you?
At the moment, we are few but we will get there. Continuous education and evidence-based fact is the key.
Does poor nutrition often play a role in the development of diseases? Are some diseases more prevalent in people following a conventional western diet?
Developed societies have witnessed an increase in autoimmune diseases in the past few years and the link between chronic inflammation and gut bacteria seems to be undeniable. Just a quick reminder: our gut thrives with a simple nutrient, fibre. It is well established that the microbiome metabolises resistant starches and dietary fibre through fermentation and decomposition, leading to the production of short-chain fatty acids. These are crucial components for the immune system and our health. So if we start reducing fibre and consuming more animal protein, the fermentation by-products of our gut microbes will be, for instance, phenolic compounds and ammonia, which are highly inflammatory and mostly carcinogenic.
Chronic inflammation is considered a major contributor to several diseases and autoimmunity activation such as cardiovascular diseases, cancer, diabetes, rheumatoid arthritis, allergic asthma, chronic kidney disease, inflammatory bowel disease, Alzheimer’s, multiple sclerosis etc.
There is growing evidence that dysbiosis (a reduction in microbial diversity of the gut) is a concerning issue for autoimmune diseases, metabolic disorders, inflammatory diseases, and functional gastrointestinal disorders and one of the major reasons for dysbiosis is a diet high in saturated fat, animal protein, refined sugar and prepared processed food.

Back in 2015, the World Health Organisation determined that processed meat – for example ham, bacon and sausages – is a major contributor to colorectal cancer. The organisation classified it as carcinogenic to humans.
Minimising the potential for underlying health conditions such as cardiovascular disease, obesity and type 2 diabetes is crucial for protecting against all autoimmune illnesses and, indeed, Covid-19. As fruits, vegetables, whole grains and beans help reduce inflammation in the body and promote a healthy immune system, diet could play a significant role.
Why do you think nutrition plays such an important part in fighting disease? Why plant based? And what exactly do you mean by this?
The immune system and microbiota – the micro-organisms found in all multicellular organisms, including the plants we eat and ourselves – are deeply intertwined. In fact, there is evidence that the microbiota enhances our infection-fighting power by helping to foster the proper development of immune cells. The microbiota also helps immune cells to identify and eradicate threats. So when we take care of our gut microbes, they take care of our immune system. This decreases our risk of autoimmune or allergic illnesses, among other problems.
If we don’t attend to this, the immune system may get weak and inadequate, exposing us to increased risk of infection or parasites such as blastocystis. The bottom line is that we want a healthy immune system, and to get there you need a healthy gut.
So how do we optimise this gut-immune connection? The answer again is to hit that fibre so you will have the optimum production of short-chain fatty acids. They go to work fixing the lining of the colon, reversing the damage of dysbiosis.
So if you want to support your immune system it’s really quite simple. Eat more plants, in abundance and diversity, and let the fibre do the work for you.

The plant-based diet I promote to my patients has four basic rules:
- It needs to be rich in complex carbohydrates: quinoa, millet, buckwheat, barley, and wholewheat pasta.
- It should be high in fibre: gut microbes are waiting to thrive and support immune function and the brain through the gut-brain axis (oats, pulses, barley, vegetables and fruits, fermented products).
- Eat like you have a rainbow on your plate – at least five or six different veggies with different colours and the same number of portions of fruits daily. Try to combine fruits with veggies in smoothies or green leafy veggies with some nuts, apples and raisins.
- Avoid processed foods, although occasionally you can have some sugar or your favourite plant-based burger since no one is perfect. It’s important to remember to make your plant-based nutrition a lifestyle, not just another unsustainable diet.
What about the vegan diet? Yes, a vegan diet can be unhealthy since the core idea of a vegan diet is to care for the planet and not hurt animals, so a person who follows a vegan diet won’t necessarily go through all the ingredients to check the salt or sugar content in a specific product. But there is a simple solution… choose both. WFPB for your health and vegan for our planet.
Is there much scientific research backing up the advantages of adopting a WFPB diet?
Yes. Recent studies have shown that just two weeks on a low-fibre diet causes altered gut microbiota that literally starts to eat away the intestinal lining, causing breakdown of the protective barrier and susceptibility to disease. Other studies point to a WFPB diet leading to a significant reduction in the risk of heart disease, type 2 diabetes, obesity and certain cancers. It has also been seen to reverse type 2 diabetes, enable effective and sustained weight loss without portion control or exercise, and arrest the progression of early stage prostate cancer.
But how many studies do we really need to accept a simple fact? Plant foods are packed with antioxidants and phytonutrients which are great for our health.
I’ve heard people talk about “leaky gut syndrome”. What exactly is it?
Leaky gut syndrome refers to damage in the seals of the bowel lining, so germs, toxins or other substances can be absorbed into the bloodstream via porous (“leaky”) gut tissue and can promote an inflammatory cascade, activating the immune system in the “wrong” way.
There is very little evidence about this and no diagnostic tool at the moment to diagnose a leaky gut.
What are your views and experience when it comes to gluten?
Several autoimmune conditions seem to share the HLA gene responsible for regulating the immune system, which suggests that coeliac disease could be an underlying factor in autoimmune conditions. As health professionals, we need to be careful in suggesting that patients follow a gluten-free diet without solid evidence and certain diagnosis, since grains are beneficial for the microbiome. Also, following a gluten-free diet can put more stress on patients on top of their diagnosis.

On the other hand, we cannot underestimate patients who report discomfort with foods that contain gluten. Non-coeliac gluten sensitivity might be a possibility and we have to take it into consideration. A trial with a natural gluten-free diet (meaning no gluten-free products packed with preservatives) for a period of around six weeks before reintroducing gluten in certain amounts could provide some answers.
Whatever the case, it’s important to seek advice from a dietitian specialising in such conditions. You certainly don’t need nutrient deficiencies to deal with on top of your autoimmunity problems.
My main aim is to share the knowledge of a plant-based lifestyle with people who suffer with chronic and autoimmune disease. I firmly believe that every person is unique. No matter the distance, I am here to help you explore what works best for you through a personalised whole plant-based lifestyle – not a diet – and feel “yourself” again.
* * * * * * * * * *
Eating plant-based, as Despina explains it, doesn’t have to be hard: stews, casseroles, soups, stir-fries and Buddha bowls are all relatively easy to whip up. Serve these with quinoa, brown rice or roast sweet potatoes. For all the above, combinations of fresh or frozen vegetables, nuts, seeds and pulses are basically cooked together in a vegetable stock with herbs and spices of your choosing. Start by googling “vegan one pot recipes”, and then play around with tastes and textures that work for you.
For stews, the vegetables are cut in chunks, and quinoa or lentils, for example, can be cooked in the same pan for a one-pot meal. Casseroles are the same, but with the pot going into the oven rather than being cooked on a hob.
It doesn’t really matter what vegetables you use. Potatoes and carrots are a good base, and from there you can add whatever you fancy, or whatever you have in the fridge. Lentils are great in these dishes. They are an excellent source of B vitamins, iron, magnesium, potassium and zinc as well as protein and fibre.
Soups are made from the same combinations, cooked and whizzed with a hand blender. Stir-fries are super quick; flash-fry the vegetables with some tofu or tempeh. Buddha bowls are combinations of nuts, seeds, pine nuts, tofu, quinoa and vegetables served together cold with a light sauce. You can make a simple, tasty sauce with tamari, a little hot water and peanut butter.

If you can, invest in a blender or specialist smoothie maker too. Quick, easy and filling, smoothies can be a reliable powerhouse. Just chuck in what you feel like, and there’s a balanced diet in a cup.
With these things in mind, here is Despina’s weekly shopping list to support immunity and a healthy gut microbiome:
Wheat products and pseudograins: Oats, quinoa, millet, wild rice, whole grain pasta.
Vegetables: Sweet potatoes, carrots, mushrooms, pumpkin, cauliflower, peppers, broccoli, beetroot, tomatoes, cucumber, at least two types of leafy greens.
Pulses: Beluga, lentils, mung beans, soya beans/edamame, chickpeas.
Fruits: Frozen berries, dried fruits, avocado, kiwi, apples, oranges… fill your fridge, freezer and fruit bowl with your own favourites.
Nuts and seeds: Almond or peanut butter, tahini paste, walnuts, pumpkin seeds, chia seeds, flaxseeds.
Herbs and spices: Turmeric and pepper, mustard powder, oregano, thyme, basil, curry and saffron.
These are some of the basics for developing a healthy approach to food. Experiment with what works for you. It might take time, but the rewards of finding your body’s ideal diet can be well worth the effort. It’s hard to give up the things we think of as treats. We live in a society in which the concept of “Go on, you deserve it” floods our social media feeds and filters through into popular thinking.
But perhaps what you deserve more is to feel the revitalisation possible through ditching greasy, sugar-rich, plastic-wrapped, addictive but artificial consumables and replacing them with the honest-to-goodness natural food that your body craves.
As Despina says, we don’t need fancy diets. All we need is real food and to feel ourselves again.
- To find out more about Despina’s work, visit her website here.
